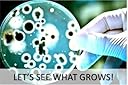
Thumbnail 7

We remain fully operational. Our teams are working around the clock to ensure your deliveries continue safely.
Copyright © 2025 Desertcart Holdings Limited

Buy anything from 5,000+ international stores. One checkout price. No surprise fees. Join 2M+ shoppers on Desertcart.
Desertcart purchases this item on your behalf and handles shipping, customs, and support to Colombia.
🧬 Cultivate curiosity, not just bacteria—be the science hero of your circle!
The Essential 2.0 Bacteria Growing Science Kit offers 10 pre-poured 100mm agar plates, sterile swabs, gloves, and a free project guide eBook, enabling kids aged 6+ to safely and easily explore microbiology with lab-grade materials made in the USA. Ideal for STEM education and science fair projects, this all-in-one kit delivers hands-on learning without the hassle of pouring agar.
| Product Dimensions | 10.16 x 10.16 x 15.24 cm; 399 g |
| Manufacturer recommended age | 6 years and up |
| Manufacturer reference | DSCI-1035 |
| Educational Objective(s) | STEM |
| Assembly Required | No |
| Batteries Required? | No |
| Batteries Included? | No |
| ASIN | B08PHBKRY4 |
J**L
Nice kit
Nice, affordable kit to get started on working with growing bacteria. Pre-sterilized so there is less risk of contamination when attempting to isolate a colony.
Trustpilot
3 weeks ago
1 day ago